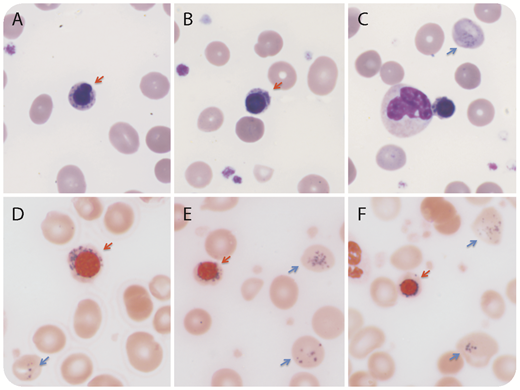
A 70-year-old woman presented with fatigue and splenomegaly. She had an 8-year history of polycythemia vera and had been diagnosed with secondary hemolytic anemia 2 years previously. Molecular analysis demonstrated a JAK2 V617F mutation. Laboratory testing revealed the following: hemoglobin, 37 g/L; reticulocyte, 16.56%; white blood cell count, 44.05 × 109/L; platelet, 565 × 109/L; and evidence of hemolysis (indirect bilirubin, 109.1 μmol/L; lactate dehydrogenase, 2362 U/L; immunoglobulin G+ by Coombs test). Serum iron and ferritin were increased. CD55 and CD59 expressions were normal. Secondary hemolytic anemia was diagnosed. Wright-Giemsa staining of peripheral blood smears (panels A-C, original magnification ×1000) demonstrated numerous nucleated red blood cells (54/100 white blood cells) with 27% ring sideroblasts (red arrow). Numerous inclusions (Pappenheimer bodies, blue arrow) were also present in the erythrocytes. Prussian blue staining confirmed the inclusions were iron positive (panels D-F, original magnification ×1000). Gene sequencing revealed wild-type SF3B1. The patient received a blood transfusion and was treated with dexamethasone and immune globulin. One week later, her hemoglobin level had increased to 107 g/L and ring sideroblasts were absent in the blood smear. / This case is a rare example of the transient presence of numerous ring sideroblasts and Pappenheimer bodies in the peripheral blood in the acute phase of hemolytic anemia secondary to polycythemia vera.

A 70-year-old woman presented with fatigue and splenomegaly. She had an 8-year history of polycythemia vera and had been diagnosed with secondary hemolytic anemia 2 years previously. Molecular analysis demonstrated a JAK2 V617F mutation. Laboratory testing revealed the following: hemoglobin, 37 g/L; reticulocyte, 16.56%; white blood cell count, 44.05 × 109/L; platelet, 565 × 109/L; and evidence of hemolysis (indirect bilirubin, 109.1 μmol/L; lactate dehydrogenase, 2362 U/L; immunoglobulin G+ by Coombs test). Serum iron and ferritin were increased. CD55 and CD59 expressions were normal. Secondary hemolytic anemia was diagnosed. Wright-Giemsa staining of peripheral blood smears (panels A-C, original magnification ×1000) demonstrated numerous nucleated red blood cells (54/100 white blood cells) with 27% ring sideroblasts (red arrow). Numerous inclusions (Pappenheimer bodies, blue arrow) were also present in the erythrocytes. Prussian blue staining confirmed the inclusions were iron positive (panels D-F, original magnification ×1000). Gene sequencing revealed wild-type SF3B1. The patient received a blood transfusion and was treated with dexamethasone and immune globulin. One week later, her hemoglobin level had increased to 107 g/L and ring sideroblasts were absent in the blood smear.
This case is a rare example of the transient presence of numerous ring sideroblasts and Pappenheimer bodies in the peripheral blood in the acute phase of hemolytic anemia secondary to polycythemia vera.
A 70-year-old woman presented with fatigue and splenomegaly. She had an 8-year history of polycythemia vera and had been diagnosed with secondary hemolytic anemia 2 years previously. Molecular analysis demonstrated a JAK2 V617F mutation. Laboratory testing revealed the following: hemoglobin, 37 g/L; reticulocyte, 16.56%; white blood cell count, 44.05 × 109/L; platelet, 565 × 109/L; and evidence of hemolysis (indirect bilirubin, 109.1 μmol/L; lactate dehydrogenase, 2362 U/L; immunoglobulin G+ by Coombs test). Serum iron and ferritin were increased. CD55 and CD59 expressions were normal. Secondary hemolytic anemia was diagnosed. Wright-Giemsa staining of peripheral blood smears (panels A-C, original magnification ×1000) demonstrated numerous nucleated red blood cells (54/100 white blood cells) with 27% ring sideroblasts (red arrow). Numerous inclusions (Pappenheimer bodies, blue arrow) were also present in the erythrocytes. Prussian blue staining confirmed the inclusions were iron positive (panels D-F, original magnification ×1000). Gene sequencing revealed wild-type SF3B1. The patient received a blood transfusion and was treated with dexamethasone and immune globulin. One week later, her hemoglobin level had increased to 107 g/L and ring sideroblasts were absent in the blood smear.
This case is a rare example of the transient presence of numerous ring sideroblasts and Pappenheimer bodies in the peripheral blood in the acute phase of hemolytic anemia secondary to polycythemia vera.
For additional images, visit the ASH Image Bank, a reference and teaching tool that is continually updated with new atlas and case study images. For more information, visit http://imagebank.hematology.org.
This feature is available to Subscribers Only
Sign In or Create an Account Close Modal